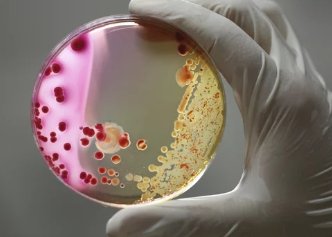
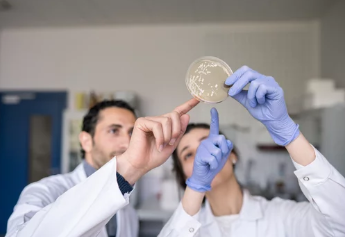

박테리아와 바이러스의 차이점 – 정의, 구조, 번식 방식, 치료 방법, 예방법, 주요 질병 비교
- 카테고리 없음
- 2025. 2. 16. 15:40
박테리아와 바이러스의 차이점 – 정의, 구조, 번식 방식, 치료 방법, 예방법, 주요 질병 비교
박테리아와 바이러스는 모두 질병을 유발할 수 있는 미생물이지만, 구조, 번식 방식, 치료 방법에서 큰 차이가 있다.
일반적으로 박테리아는 항생제로 치료가 가능하지만, 바이러스 감염은 항생제로 치료되지 않고 백신이나 항바이러스제가 필요하다.
이번 글에서는 박테리아와 바이러스의 차이점, 구조적 특징, 감염 방식, 치료 및 예방 방법을 상세히 설명하겠다.
1. 박테리아와 바이러스의 정의 및 주요 차이점



① 박테리아(Bacteria)란?
✔ 단세포 생물로, 독립적인 생명체이며 세포 구조(세포막, 세포벽 등)를 가지고 있음
✔ 자체적으로 번식 가능하며, 자연계에서 유익한 역할도 수행 (예: 장내 유익균)
✔ 일부 박테리아는 질병을 유발할 수 있음 (예: 폐렴균, 결핵균)
② 바이러스(Virus)란?
✔ 세포 구조가 없는 비생명체로, 숙주 세포에 기생해야만 증식 가능
✔ 단백질 껍질(캡시드)과 유전물질(DNA 또는 RNA)로 구성됨
✔ 자체적으로 번식이 불가능하며, 숙주의 세포를 이용해 증식
📌 즉, 박테리아는 독립적인 생명체지만, 바이러스는 숙주 없이 증식할 수 없는 기생성 입자이다.
2. 박테리아와 바이러스의 구조적 차이



구분 박테리아 바이러스
| 세포 구조 | 있음 (세포막, 세포벽, 리보솜 보유) | 없음 (단백질 껍질 + 유전물질) |
| 생명체 여부 | 독립적인 생명체 | 비생명체 (숙주 필요) |
| 유전물질 | DNA | DNA 또는 RNA |
| 크기 | 0.1~5㎛ (바이러스보다 큼) | 0.02~0.3㎛ (박테리아보다 작음) |
| 번식 방식 | 세포 분열 | 숙주 세포 감염 후 복제 |
📌 즉, 박테리아는 세포 구조를 가지지만, 바이러스는 세포 구조가 없으며 독립적으로 생존할 수 없다.
3. 감염 방식 및 질병 유발 차이



① 박테리아 감염 (세포 분열을 통해 증식 & 조직 손상 유발)
✔ 자체적으로 성장 & 분열하며 독소를 생성해 인체에 해를 끼칠 수 있음
✔ 일부 박테리아는 장내 유익균처럼 유익한 역할을 수행하기도 함
✔ 대표적인 박테리아 감염 질환: 폐렴, 결핵, 식중독, 방광염, 탄저병
② 바이러스 감염 (숙주 세포를 이용해 복제 & 면역 시스템 공격)
✔ 단독으로 증식할 수 없으며, 숙주의 세포를 감염시켜 유전물질을 복제
✔ 면역세포를 공격하여 신체 기능을 약화시킬 수 있음
✔ 대표적인 바이러스 감염 질환: 감기, 독감, 코로나19, 에이즈(HIV), 수두, 간염, 홍역
📌 즉, 박테리아는 자체적으로 증식하며 일부는 유익균이 될 수도 있지만, 바이러스는 숙주 세포를 감염시켜 증식한다.
4. 박테리아와 바이러스의 치료 방법 차이

① 박테리아 감염 치료 – 항생제 사용 가능
✔ 박테리아 감염은 항생제(페니실린, 세팔로스포린 등)를 이용해 치료 가능
✔ 항생제는 박테리아의 세포벽을 파괴하거나 단백질 합성을 방해하여 성장 억제
✔ 하지만 남용할 경우 내성균(슈퍼박테리아) 발생 위험 있음
② 바이러스 감염 치료 – 백신 & 항바이러스제 사용
✔ 항생제로 치료 불가능 (바이러스는 세포벽이 없고 자체 대사가 없기 때문)
✔ 백신(독감, 간염, HPV 등)으로 예방 가능
✔ 일부 바이러스 감염은 항바이러스제(타미플루, 렘데시비르, 아시클로버 등)로 치료 가능
📌 즉, 박테리아는 항생제로 치료 가능하지만, 바이러스 감염은 백신 및 항바이러스제를 이용해야 한다.
5. 예방 방법 차이

① 박테리아 감염 예방 방법
✔ 손 씻기 & 개인 위생 철저히 하기
✔ 음식물 충분히 익혀 먹기 (식중독 예방)
✔ 항생제 남용 금지 (내성균 예방)
② 바이러스 감염 예방 방법
✔ 백신 접종 필수 (독감, A형/B형 간염, 코로나19 등)
✔ 기침 예절 준수 (마스크 착용 & 손 씻기)
✔ 면역력 강화 (충분한 영양 섭취 & 운동)
📌 즉, 박테리아는 위생 관리가 중요하며, 바이러스는 백신 접종이 필수적이다.
6. 박테리아와 바이러스 감염 주요 질병 비교
감염 유형 박테리아 감염 바이러스 감염
| 호흡기 질환 | 폐렴, 결핵 | 감기, 독감, 코로나19 |
| 소화기 질환 | 식중독, 장티푸스 | 노로바이러스, A형 간염 |
| 피부 질환 | 괴저, 농가진 | 수두, 대상포진 |
| 성병 | 임질, 매독 | HIV(에이즈), HPV(자궁경부암) |
📌 즉, 같은 부위(호흡기, 소화기 등)를 감염시키더라도 원인에 따라 치료 방법이 다를 수 있다.
결론 – 박테리아와 바이러스의 핵심 차이점 정리
✅ 박테리아는 세포 구조를 가진 독립적인 생명체이며, 바이러스는 숙주가 없으면 증식할 수 없는 기생성 입자
✅ 박테리아 감염은 항생제로 치료 가능하지만, 바이러스 감염은 항생제로 치료되지 않음
✅ 박테리아 감염은 위생 관리가 중요하며, 바이러스 감염은 백신 접종이 가장 효과적인 예방 방법
✅ 대표적인 박테리아 감염병: 폐렴, 결핵, 식중독, 탄저병
✅ 대표적인 바이러스 감염병: 감기, 독감, 코로나19, HIV, 간염
📌 박테리아와 바이러스는 감염 방식과 치료 방법이 다르므로, 정확한 진단과 예방이 중요하다.